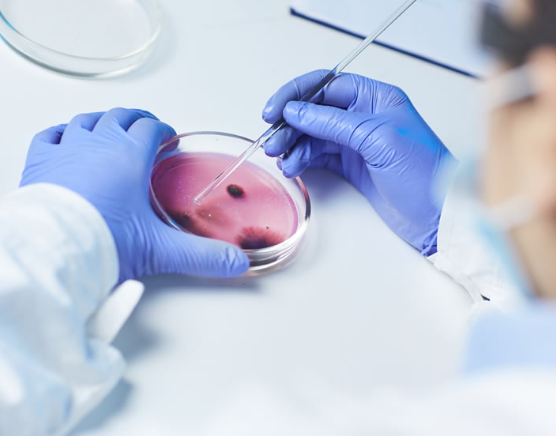
Gallery thumbnail

yext
Casa di Cura Privata Santa Teresa Owner verified
Via Nazionale, 7/25 03036, Isola del Liri, FRLast time updated: 3/3/26, 12:09 AM
About
Lo staff della Casa di Cura privata Santa Teresa altamente qualificato e composto da medici di grande spessore, sarà lieto di poter assistere i pazienti, essendo accreditata con il SSR per ortopedia e traumatologia, chirurgia, cardiologia, diagnostica per immagini, analisi chimico cliniche. Da oltre 60 anni la Casa di Cura è al servizio dei suoi clienti con professionalità e serietà, offrendo la possibilità di visite, servizi diagnostici e terapeutici, in molteplici branche sia mediche che chirurgiche.
Images

Gallery Cliente

Gallery Cliente

Gallery Cliente
Gallery Cliente

Gallery Cliente

Gallery Cliente

Gallery Cliente

Gallery Cliente

Gallery Cliente

Gallery Cliente
Frequently Asked Questions
Which days is Casa di Cura Privata Santa Teresa open?
Open on Monday, Tuesday, Wednesday, Thursday, Friday, Saturday, Sunday.
Attention business owner!
Register your business now and enhance your global reach with iGlobal.
Copied to clipboard!